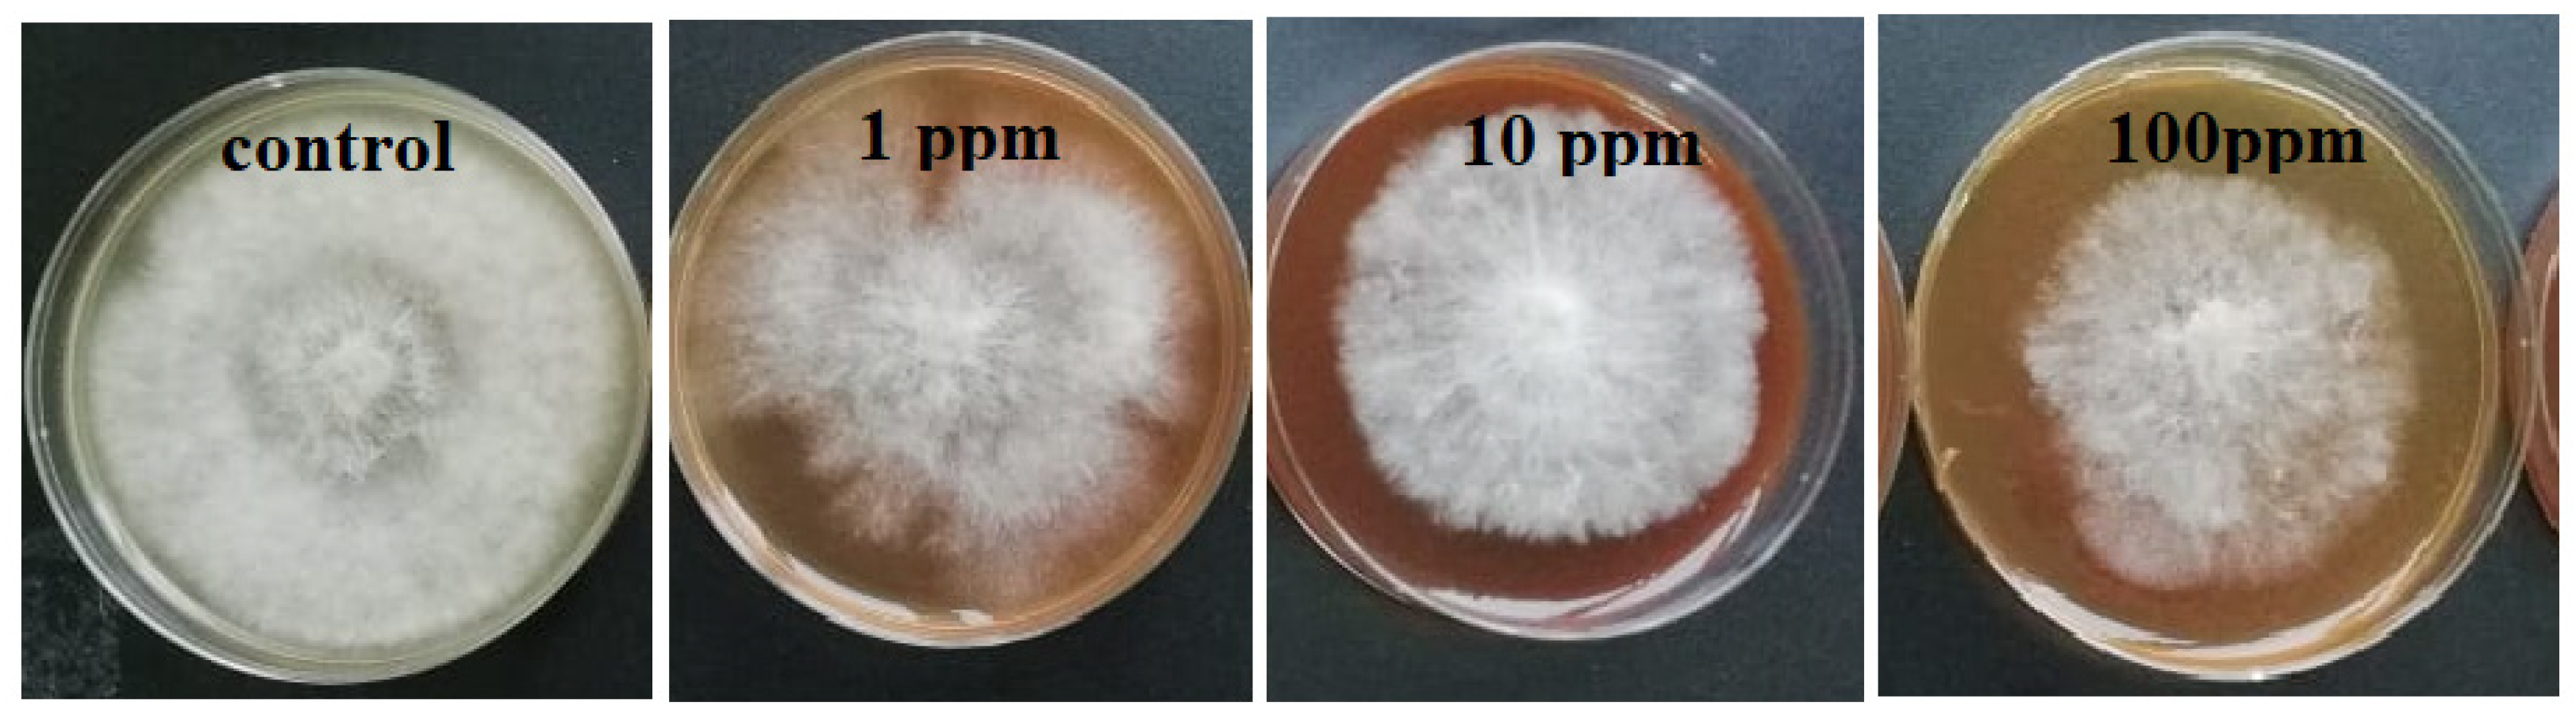
Molecules 26 05402 g002 550
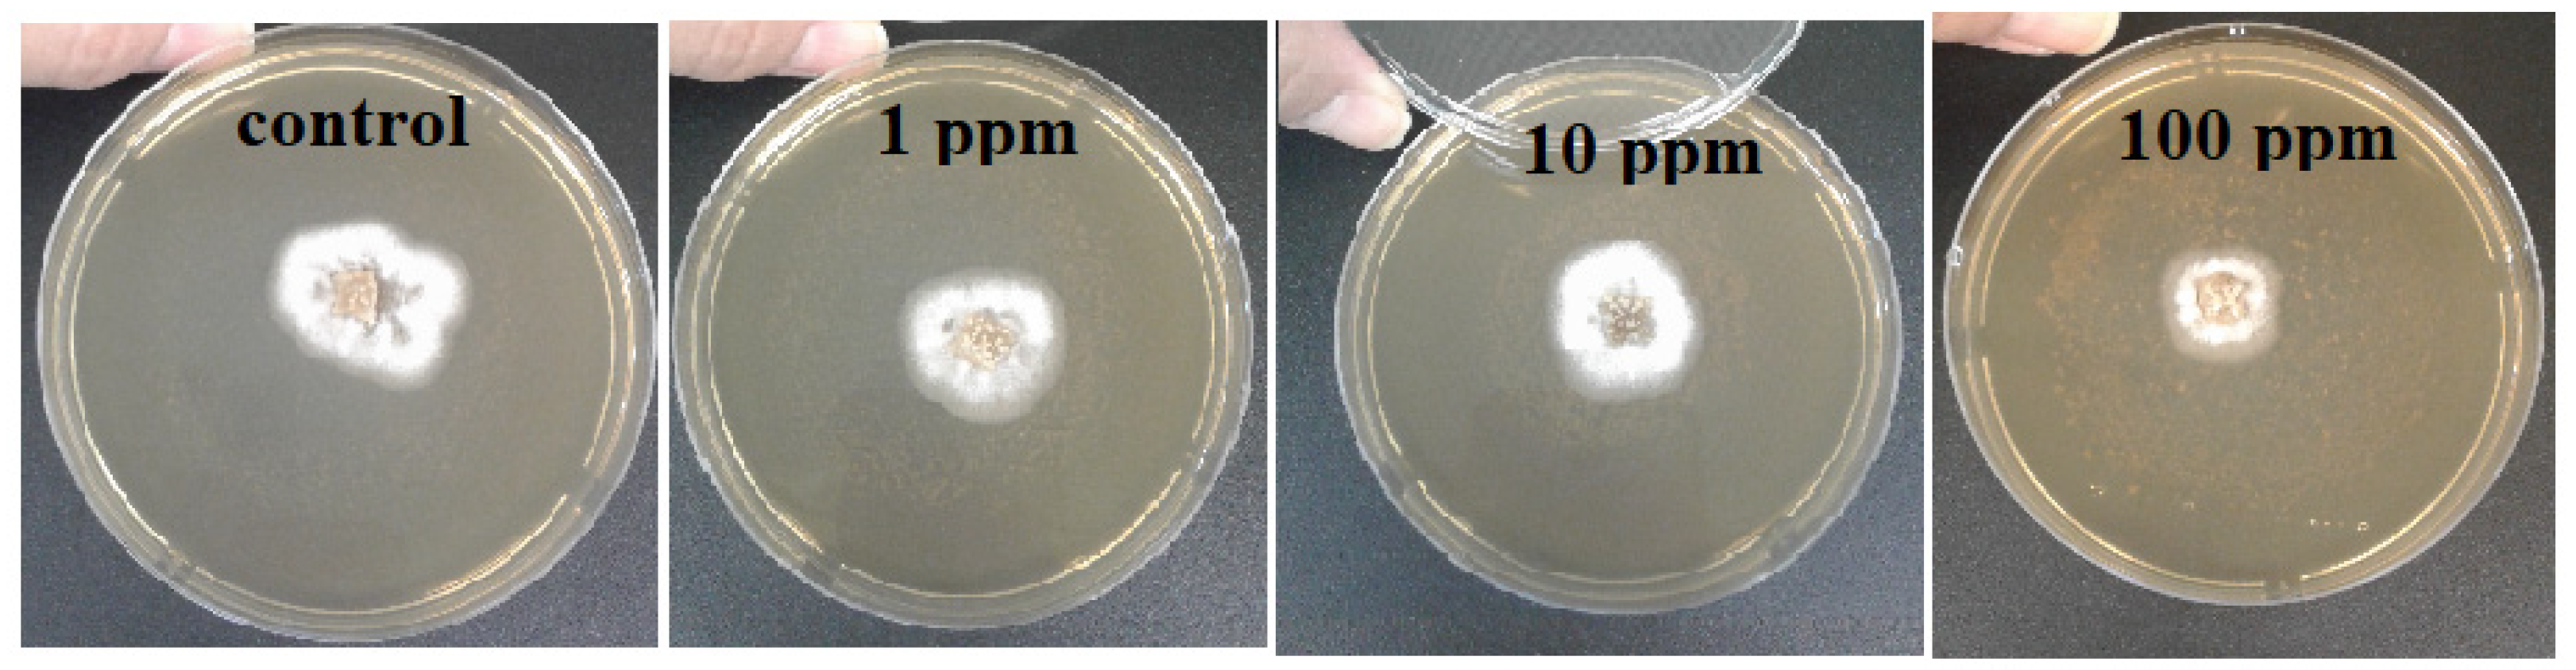
Molecules 26 05402 g003 550
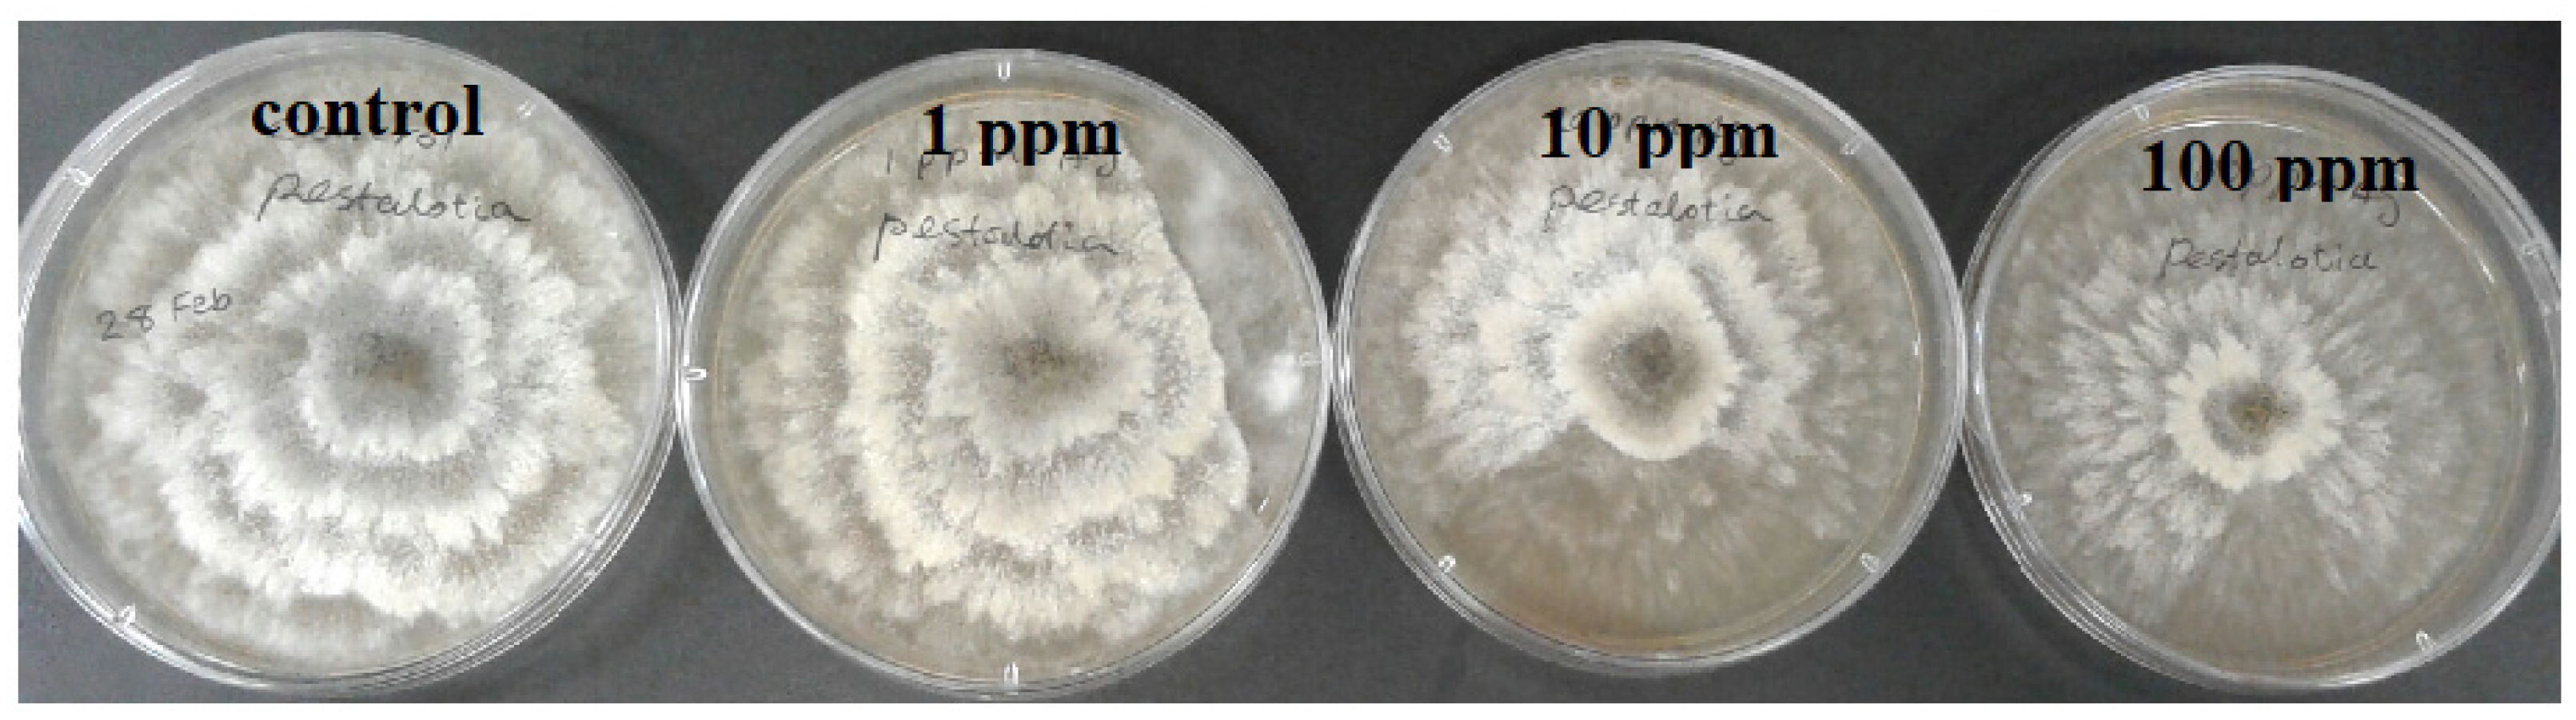
Molecules 26 05402 g004 550
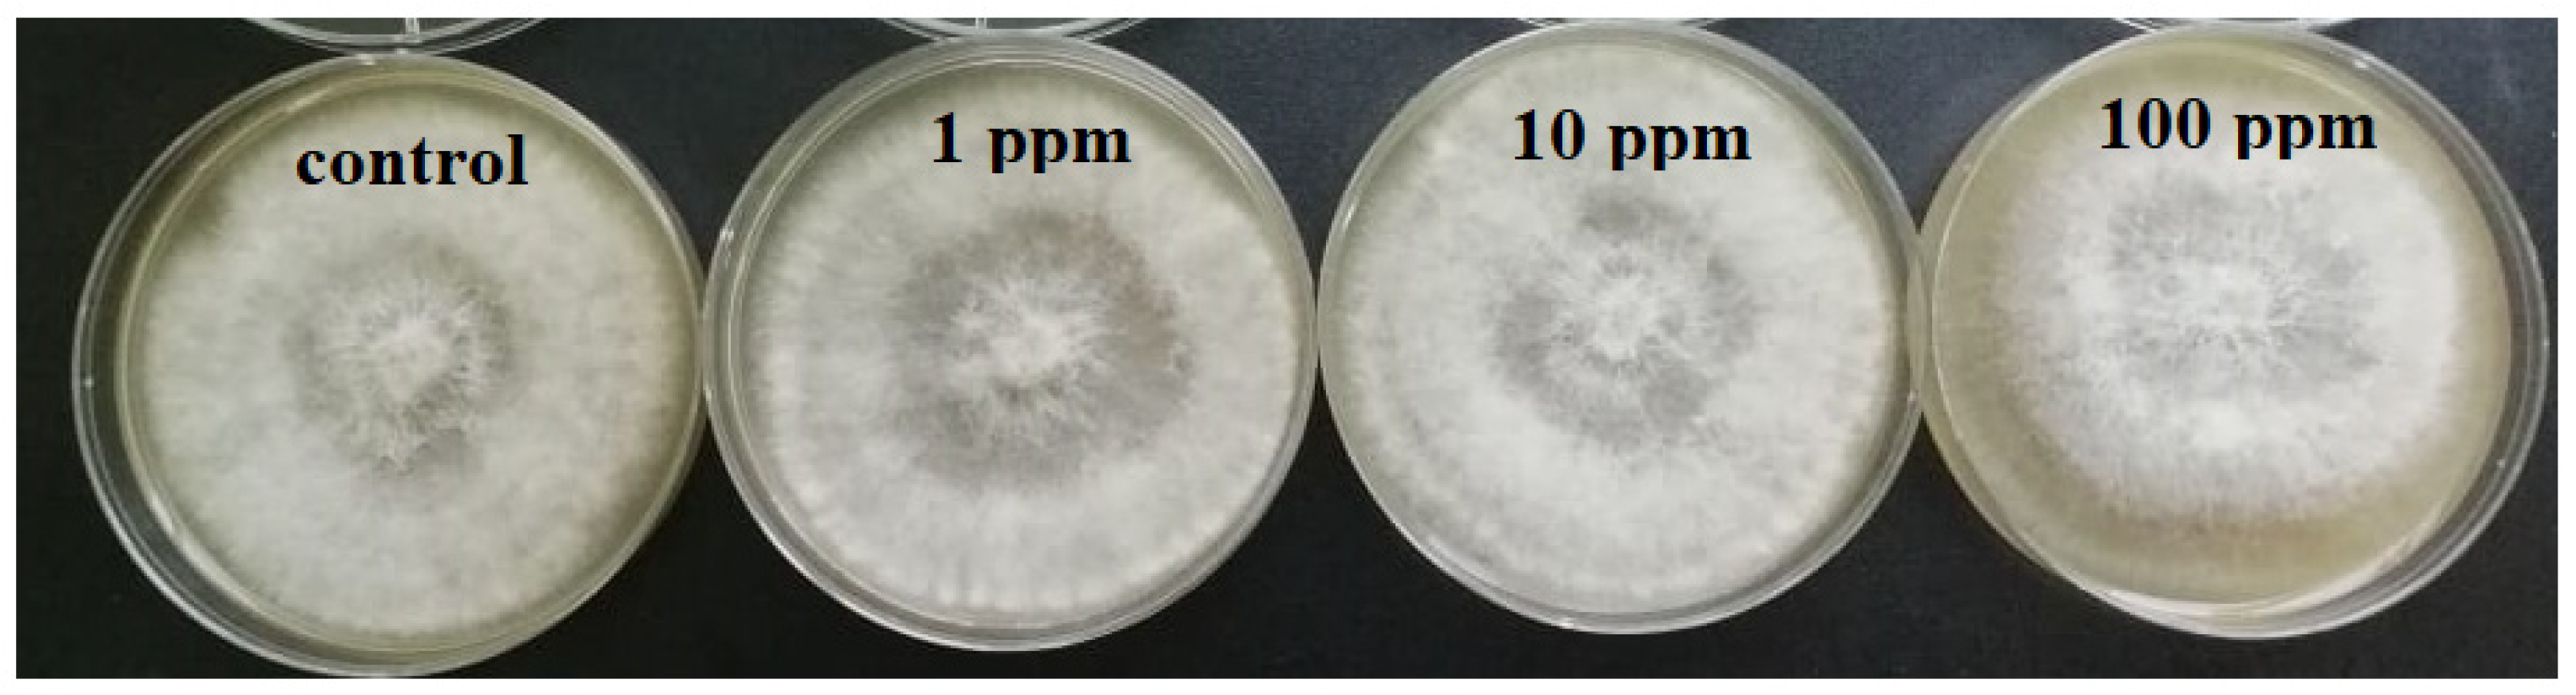
Molecules 26 05402 g006 550

In Vitro Evaluation of Antibacterial and Antifungal Activity of Biogenic Silver and Copper Nanoparticles: The First Report of Applying Biogenic Nanoparticles against Pilidium concavum and Pestalotia sp. Fungi
Abstract
:1. Introduction
2. Results and Discussion
2.1. In Vitro Evaluation of Antibacterial Activity of Biogenic Ag and Cu Nanoparticles
2.2. In Vitro Evaluation of Antifungal Activity of Synthesized Ag Nanoparticles
2.3. In Vitro Evaluation of Antifungal Activity of Biogenic Cu Nanoparticles
3. Materials and Methods
3.1. In Vitro Evaluation of Antibacterial Activity of Ag and Cu Biogenic Nanoparticles
3.2. In Vitro Evaluation of Antifungal Activity of Biogenic Nanoparticles
4. Conclusions
Author Contributions
Funding
Institutional Review Board Statement
Informed Consent Statement
Data Availability Statement
Acknowledgments
Conflicts of Interest
Sample Availability
References
- Gondwal, M.; Joshi nee Pant, G. Synthesis and Catalytic and Biological Activities of Silver and Copper Nanoparticles Using Cassia occidentalis. Int. J. Biomater. 2018, 2018, 6735426. [Google Scholar] [CrossRef] [PubMed] [Green Version]
- Gultekin, D.; Gungor, A.; Onem, H.; Babagil, A.; Nadaroglu, H. Synthesis of Copper Nanoparticles Using a Different Method: Determination of Their Antioxidant and Antimicrobial Activity. JOTCSA 2016, 3, 623–636. [Google Scholar]
- Nasrollahzadeh, M.; Mohammad Sajadib, S.; Khalaj, M. Green synthesis of copper nanoparticles using aqueous extract of the leaves of Euphorbia esula L and their catalytic activity for ligand-free Ullmann coupling reaction and reduction of 4-nitrophenol. RSC Adv. 2014, 4, 47313. [Google Scholar] [CrossRef]
- Roy, R.; Bulut, O.; Some, S.; Manda, A.K.; Yilmaz, D. Green synthesis of silver nanoparticles: Biomolecule-nanoparticle organizations targeting antimicrobial activity. RSC Adv. 2019, 9, 2673. [Google Scholar] [CrossRef] [Green Version]
- Siddiqi, K.S.; Rahman, A.; Husen, A. Properties of Zinc Oxide Nanoparticles and Their Activity against Microbes. Nanoscale Res. Lett. 2018, 13, 141. [Google Scholar] [CrossRef]
- Krutyakov, Y.; Kudrinskiy, A.; Zherebin, P.; Yapryntsev, A.; Pobedinskaya, M.; Elansky, S.; Denisov, A.; Mikhaylov, D.; Lisichkin, G. Tallow amphopolycarboxyglycinate-stabilized silver nanoparticles: New frontiers in development of plant protection products with a broad spectrum of action against phytopathogens. Mater. Res. Express 2016, 3, 1–9. [Google Scholar] [CrossRef]
- Brandelli, A.; Carolina Ritter, A.; Fonseca Veras, F. Chapter 15, Antimicrobial Activities of Metal Nanoparticles; Springer: Berlin/Heidelberg, Germany, 2017. [Google Scholar] [CrossRef]
- Narware, J.; Yadav, R.; Keswani, S.; Singh, S.P.; Singh, H.B. Chapter 13, Silver Nanoparticlebased Biopesticides for Phytopathogens: Scope and Potential in Agriculture, Nano-Biopesticides Today and Future Perspectives; Elsevier Inc.: Amsterdam, The Netherlands, 2019. [Google Scholar] [CrossRef]
- Khashan, K.S.; Sulaiman, G.M.; Abdulameer, F.A. Synthesis and Antibacterial Activity of CuO Nanoparticles Suspension Induced by Laser Ablation in Liquid. Arab. J. Sci. Eng. 2016, 41, 301–310. [Google Scholar] [CrossRef]
- Chung, M.; Rahuman, A.; Marimuthu, S.; Kirthi, A.; Anbarasan, K.; Padmini, P.; Rajakumar, G. Green synthesis of copper nanoparticles using Eclipta prostrata leaves extract and their antioxidant and cytotoxic activities. Exp. Ther. Med. 2017, 14, 18–24. [Google Scholar] [CrossRef] [PubMed] [Green Version]
- Nagar, N.; Devra, V. Green synthesis and characterization of copper nanoparticles using Azadirachta indica leaves. Mater. Chem. Phys. 2018, 213, 44–51. [Google Scholar] [CrossRef]
- Mandava, K.; Kadimcharla, K.; Keesara, N.R.; Fatima, S.N.; Bommena, P.; Batchu, U.R. Green Synthesis of Stable Copper Nanoparticles and Synergistic Activity with Antibiotics. Indian J. Pharm. Sci. 2017, 79, 695–700. [Google Scholar] [CrossRef]
- Vinutha Moses, S.G.; Ananda, S. Biological Synthesis of Copper Nanoparticles and its impact—A Review. Int. J. Pharm. Sci. Invent. 2014, 3, 28–38. [Google Scholar]
- Iravani, S. Green synthesis of metal nanoparticles using plants. Green Chem. 2011, 13, 2638. [Google Scholar] [CrossRef]
- Al-Hakkani, M. Biogenic copper nanoparticles and their applications: A review. SN Appl. Sci. 2020, 2, 505. [Google Scholar] [CrossRef] [Green Version]
- Vijayaraghavan, K.; Nalini, S.K. Biotemplates in the green synthesis of silver nanoparticles. Biotechnol. J. 2010, 5, 1098–1110. [Google Scholar] [CrossRef] [PubMed]
- Divya, N.T.; Gautam, Y.K. Facile green synthesis and applications of silver nanoparticles: A state-of-the-art review. RSC Adv. 2019, 9, 34926. [Google Scholar] [CrossRef] [Green Version]
- Bayat, M.; Zargar, M.; Astarkhanova, T.; Pakina, E.; Ladan, S.; Lyashko, M.; Shkurkin, S. Facile biogenic synthesis and characterization of seven metal-based nanoparticles conjugated with phytochemical bioactives using fragaria ananassa leaf extract. Molecules 2021, 26, 3025. [Google Scholar] [CrossRef] [PubMed]
- Walker, T.S.; Bais, H.P.; Déziel, E.; Schweizer, H.P.; Rahme, L.G.; Fall, R.; Vivanco, J.M. Pseudomonas aeruginosa-Plant Root Interactions. Pathogenicity, Biofilm Formation, and Root Exudation. Plant Physiol. 2004, 134, 320–331. [Google Scholar] [CrossRef] [PubMed] [Green Version]
- Govrin, E.M.; Levine, A. The hypersensitive response facilitates plant infection by the necrotrophic pathogen. Botrytis cinerea. Curr. Biol. 2000, 10, 751–757. [Google Scholar] [CrossRef] [Green Version]
- Fernández-Ortuño, D.; Bryson, P.K.; Schnabel, G. First Report of Pilidium concavum Causing Tan-brown Rot on Strawberry Nursery Stock in South Carolina. Plant Dis. 2014, 98, 1010. [Google Scholar] [CrossRef]
- Moshayedi, M.; Rahanandeh, H.; Hamzeh, A. In vitro evaluation of some fungicides and tea extract against Pestalotia sp. and Colletotrichum sp., the causal agents of leaf spot and anthracnose of azalea. J. Ornam. Plants 2017, 7, 45–51. [Google Scholar]
- Karaman, D.S.; Manner, S.; Fallarero, A.; Jessica, M. Current Approaches for Exploration of Nanoparticles as Antibacterial Agents. Antibact. Agent 2017. [Google Scholar] [CrossRef] [Green Version]
- Punjabi, K.; Mehta, S.; Chavan, R.; Chitalia, V.; Deogharkar, D.; Deshpande, S. Efficiency of Biosynthesized Silver and Zinc Nanoparticles Against Multi-Drug Resistant Pathogens. Front. Microbiol. 2018, 9, 2207. [Google Scholar] [CrossRef] [PubMed] [Green Version]
- Okafor, F.; Janen, A.; Kukhtareva, T.; Edwards, V.; Curley, M. Green Synthesis of Silver Nanoparticles, Their Characterization, Application and Antibacterial Activity. Int. J. Environ. Res. Public Health 2013, 10, 5221–5238. [Google Scholar] [CrossRef] [PubMed] [Green Version]
- Patra, J.K.; Baek, K.H. Antibacterial Activity and Synergistic Antibacterial Potential of Biosynthesized Silver Nanoparticles against Foodborne Pathogenic Bacteria along with its Anticandidal and Antioxidant Effects. Front. Microbiol. 2017, 8, 167. [Google Scholar] [CrossRef] [PubMed] [Green Version]
- Gorczyca, A.; Przemieniecki, S.W.; Kurowski, T.; Ocwieja, M. Early plant growth and bacterial community in rhizoplane of wheat and flax exposed to silver and titanium dioxide nanoparticles. Environ. Sci. Pollut. Res. 2018, 25, 33820–33826. [Google Scholar] [CrossRef] [PubMed] [Green Version]
- Ijaz, F.; Shahid, S.; Ahmad Khan, S.; Ahmad, W.; Zaman, S. Green synthesis of copper oxide nanoparticles using Abutilon indicum leaf extract: Antimicrobial, antioxidant and photocatalytic dye degradation activities. Trop. J. Pharm. Res. 2017, 16, 743–753. [Google Scholar] [CrossRef] [Green Version]
- Ebrahimi, K.; Shiravand, S.; Mahmoudvand, H. Biosynthesis of copper nanoparticles using aqueous extract of Capparis spinosa fruit and investigation of its antibacterial activity. Marmara Pharm. J. 2017, 21, 866–871. [Google Scholar] [CrossRef]
- Kim, S.W.; Jung, J.H.; Lamsal, K.; Kim, Y.S.; Min, J.S.; Lee, Y.S. Antifungal Effects of Silver Nanoparticles (AgNPs) against Various Plant Pathogenic Fungi. Mycobiology 2012, 40, 53–58. [Google Scholar] [CrossRef] [PubMed] [Green Version]
- Ghojavand, S.; Madani, M.; Karimi, J. Green Synthesis, Characterization and Antifungal Activity of Silver Nanoparticles Using Stems and Flowers of Felty Germander. J. Inorg. Organomet. Polym. Mater. 2020, 30, 2987–2997. [Google Scholar] [CrossRef]
- Huang, W.; Yan, M.; Duan, H.; Bi, Y.; Cheng, X.; Yu, H. Synergistic Antifungal Activity of Green Synthesized Silver Nanoparticles and Epoxiconazole against Setosphaeria turcica. J. Nanomater. 2020, 2020, 9535432. [Google Scholar] [CrossRef] [Green Version]
- Min, J.S.; Kim, K.S.; Kim, S.W.; Jung, J.H.; Lamsal, K.; Kim, S.B.; Jung, M.; Lee, Y.S. Effects of colloidal silver nanoparticles on sclerotium-forming phytopathogenic fungi. J. Plant Pathol 2009, 25, 376–380. [Google Scholar] [CrossRef]
- Mishra, S.; Keswani, C.; Singh, A.; Singh, B.R.; Singh, S.P.; Singh, H.B. Microbial nanoformulation: Exploring potential for coherent nano-farming. In The Handbook of Microbial Bioresourses; CABI: London, UK, 2016; pp. 107–120. [Google Scholar]
- Bayat, M.; Chudinova, E.; Zargar, M.; Lyashko, M.; Louis, K.; Adenew, F.K. Phyto-assisted green synthesis of zinc oxide nanoparticles and its antibacterial and antifungal activity. Res. Crop. 2019, 20, 725–730. [Google Scholar]
- Aaron, S.E.; Tosheska-Trajkovska, K.; Cekovska, S.; Aaron, J.J. Establishment of an EC50 database of pesticides using a Vibrio fischeri bioluminescence method. Luminescence 2019, 34, 508–511. [Google Scholar] [CrossRef] [PubMed]
- Balouiri, M.; Sadiki, M.; Ibnsouda, S.K. Methods for in vitro evaluating antimicrobial activity: A review. J. Pharm. Anal. 2016, 6, 71–79. [Google Scholar] [CrossRef] [Green Version]
- Koneman, E.W.; Allen, S.D.; Janda, W.M.; Schreckenberger, P.C.; Winn, J.R. Color Atlas and Textbook of Diagnostic Microbiology, 5th ed.; Lippincott-Raven Publishers: Philadelphia, PA, USA, 1997. [Google Scholar]
- Arciniegas-Grijalba, P.A.; Patino-Portela, M.C.; Mosquera-Sa´nchez, L.P.; Guerrero-Vargas, J.A.; Rodriguez-Páez, J.E. ZnO nanoparticles (ZnO-NPs) and their antifungal activity against coffee fungus Erythricium salmonicolor. Appl. Nanosci. 2017, 7, 225–241. [Google Scholar] [CrossRef] [Green Version]

| Concentration (ppm) | 6th Day Colony Diameter (mm) | 9th Day Colony Diameter (mm) | Growth Inhibition % (9th Day) |
|---|---|---|---|
| Control | 27.5 ± 0.25 | 70.5 ± 1.0 | - |
| 1 | 27.3 ± 0.25 | 66.3 ± 2.2 | 5.7 ± 1.8% |
| 10 | 11.9 ± 1.6 | 60.5 ± 3.2 | 14.25 ± 2.9% |
| 100 | 5.0 ± 0.1 | 50.3 ± 4.9 | 28 ± 4.1% |
| Concentration (ppm) | 6th Day Colony Diameter (mm) | 9th Day Colony Diameter (mm) | Growth Inhibition % (9th day) |
|---|---|---|---|
| Control | 3.5 ± 0.25 | 46.2 ± 6.5 | - |
| 1 | 1.5 ± 0.5 | 43.2 ± 4.2 | 6.5 ± 1.7% |
| 10 | 1.5 ± 0.1 | 41.6 ± 3.2 | 10 ± 2.4% |
| 100 | 0.5 ± 0.1 | 16 ± 1.0 | 65.36 ± 2.1% |
Publisher’s Note: MDPI stays neutral with regard to jurisdictional claims in published maps and institutional affiliations. |
© 2021 by the authors. Licensee MDPI, Basel, Switzerland. This article is an open access article distributed under the terms and conditions of the Creative Commons Attribution (CC BY) license (https://creativecommons.org/licenses/by/4.0/).
Share and Cite
Bayat, M.; Zargar, M.; Chudinova, E.; Astarkhanova, T.; Pakina, E. In Vitro Evaluation of Antibacterial and Antifungal Activity of Biogenic Silver and Copper Nanoparticles: The First Report of Applying Biogenic Nanoparticles against Pilidium concavum and Pestalotia sp. Fungi. Molecules 2021, 26, 5402. https://doi.org/10.3390/molecules26175402
Bayat M, Zargar M, Chudinova E, Astarkhanova T, Pakina E. In Vitro Evaluation of Antibacterial and Antifungal Activity of Biogenic Silver and Copper Nanoparticles: The First Report of Applying Biogenic Nanoparticles against Pilidium concavum and Pestalotia sp. Fungi. Molecules. 2021; 26(17):5402. https://doi.org/10.3390/molecules26175402
Chicago/Turabian StyleBayat, Maryam, Meisam Zargar, Elena Chudinova, Tamara Astarkhanova, and Elena Pakina. 2021. "In Vitro Evaluation of Antibacterial and Antifungal Activity of Biogenic Silver and Copper Nanoparticles: The First Report of Applying Biogenic Nanoparticles against Pilidium concavum and Pestalotia sp. Fungi" Molecules 26, no. 17: 5402. https://doi.org/10.3390/molecules26175402
APA StyleBayat, M., Zargar, M., Chudinova, E., Astarkhanova, T., & Pakina, E. (2021). In Vitro Evaluation of Antibacterial and Antifungal Activity of Biogenic Silver and Copper Nanoparticles: The First Report of Applying Biogenic Nanoparticles against Pilidium concavum and Pestalotia sp. Fungi. Molecules, 26(17), 5402. https://doi.org/10.3390/molecules26175402

